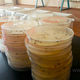

Ежегодно в Кыргызстане высаживают 6 миллионов саженцев. Об этом рассказал заместитель директора департамента развития лесных систем Госагентства охраны окружающей среды и лесного хозяйства Бактыбек Ырсалиев.
Все семена, собираемые лесхозами, проходят лабораторные исследования на соответствие стандартам. Лабораторию построили в 2014 году в рамках корейского проекта. «Мы делаем оценку и отправляем результаты обратно. Только после получения анализов происходит посев. Раньше у нас не было подобного оборудования, и анализы делал Институт леса НАН КР», — рассказал он.
Лабораторию оснастили современным оборудованием, однако пока у нее нет международной сертификации. В госагентстве отметили, что для этого необходимо выполнить ряд условий — от технических требований до кадровых.
В год в питомниках и лесхозах выращивают 16 миллионов саженцев. Около 6 миллионов из них — стандартный посадочный материал, годный к посадке.
«Это может быть четырехлетний сеянец, например, тянь-шаньской ели. Их будут высаживать в государственных лесных фондах. Есть саженцы лиственные. Тополь достигает стандарта за год», — отметил Бактыбек Ырсалиев.
По его словам, около двух миллионов саженцев ежегодно выделяют на трехмесячник по озеленению. Остальные высаживают на территориях лесного фонда для увеличения площади лесов.
Ускорить процесс роста саженцев позволяет специальный питомник-парник корейского типа по выращиванию саженцев с закрытой корневой системой.